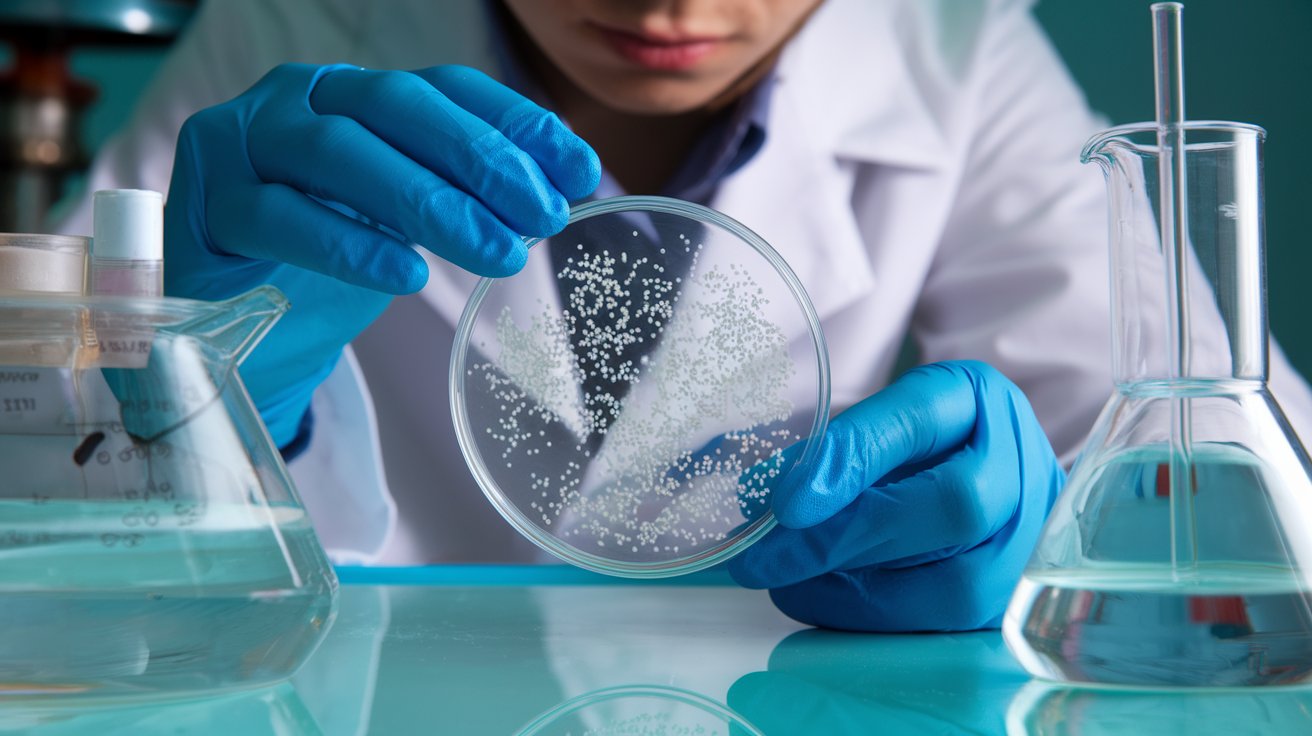

Bacillus Coagulans Benefits and Uses Details
Bacillus coagulans is a spore-forming probiotic bacterium that has gained attention for its unique characteristics and health benefits. Initially isolated from spoiled canned milk in 1915, B. coagulans is classified as a lactic acid-producing bacterium and is known for its ability to survive harsh environmental conditions due to its spore-forming capabilities. This survival mechanism allows it to maintain a higher stability compared to traditional probiotics like Lactobacillus and Bifidobacterium, which often have low survival rates in extreme environments. B. coagulans has been shown to promote intestinal digestion, regulate gut microbiota, and inhibit pathogenic bacteria, making it beneficial for gastrointestinal health. Additionally, it supports the immune system by normalizing immune parameters and enhancing immune cell activity. With its Generally Recognized As Safe (GRAS) status from the FDA, B. coagulans is increasingly utilized in functional foods, providing a promising option for improving human health and well-being. Bacillus coagulans operates through several mechanisms that contribute to its probiotic effects and overall benefits for human health: B. coagulans helps establish an anaerobic and acidic environment in the intestines, which is unfavorable for many pathogenic bacteria. This promotes the growth of beneficial probiotics like Lactobacillus and Bifidobacterium, enhancing gut health. By consuming free oxygen in the gut, B. coagulans reduces redox reactions, which can inhibit the growth of harmful microorganisms. This competitive exclusion helps maintain a balanced gut microbiota. B. coagulans has been shown to increase the concentrations of beneficial SCFAs such as butyrate, acetate, and propionate. These compounds play a crucial role in gut health by providing energy to colon cells and regulating inflammation. B. coagulans can normalize immune system parameters and enhance the functional activity of immune cells. This immune modulation is vital for protecting the host from infections and diseases. The bacterium is effective in preventing dysbiosis, which is often caused by antibiotic abuse. By increasing populations of beneficial bacteria, B. coagulans helps restore microbial balance and prevent related diseases. It is important to note that the probiotic functions of B. coagulans can vary significantly among different strains. This strain-dependent nature suggests that combining various strains may maximize the health benefits of B. coagulans in future applications. Bacillus coagulans offers a range of health benefits, primarily through its probiotic characteristics and interactions with the human body. Here are some key benefits: B. coagulans enhances the digestion of food by producing various enzymes that facilitate the breakdown of nutrients. This includes the secretion of β-galactosidase, which helps in digesting lactose, making it beneficial for individuals with lactose intolerance. The presence of B. coagulans in the gut can increase the absorption of essential nutrients, including amino acids and vitamins. This is particularly beneficial for athletes, as it can enhance the uptake of branched-chain amino acids and other important nutrients for recovery and performance. B. coagulans contributes to maintaining a healthy gut microbiota by creating an environment that is unfavorable for pathogenic bacteria. This helps in preventing infections and gastrointestinal diseases. The bacterium plays a role in normalizing immune system parameters and enhancing the functional activity of immune cells. This immune modulation can help the body better respond to infections and reduce inflammation. B. coagulans has been shown to alleviate symptoms of gastrointestinal disorders, such as constipation. Studies indicate that it can improve bowel movement frequency and overall gut function, leading to better digestive health. In addition to enzymes, B. coagulans produces metabolites like short-chain fatty acids (SCFAs) and vitamins, which contribute to gut health and overall well-being. SCFAs are known to provide energy to colon cells and have anti-inflammatory properties. Different strains of B. coagulans may offer varying health benefits. This strain-dependent nature suggests that using a combination of strains could maximize the overall health effects of B. coagulans in therapeutic applications. Bacillus coagulans has been studied for its potential role in cancer prevention, primarily through its effects on gut health and immune modulation. Here are some insights into how B. coagulans may contribute to cancer prevention: B. coagulans helps maintain a balanced gut microbiota, which is crucial for overall health. A healthy gut microbiome can prevent dysbiosis, a condition linked to inflammation and cancer development. By inhibiting the growth of pathogenic bacteria, B. coagulans may reduce the risk of gastrointestinal cancers. The bacterium has been shown to normalize immune system parameters and enhance the functional activity of immune cells. A well-functioning immune system is essential for identifying and eliminating cancerous cells. By boosting immune responses, B. coagulans may help the body combat cancer more effectively. B. coagulans produces various antimicrobial substances, including bacteriocins and organic acids like lactic acid. These compounds can inhibit the growth of harmful bacteria and potentially reduce the risk of infections that may lead to cancer. The antimicrobial properties of B. coagulans can contribute to a healthier gut environment, which is vital for cancer prevention. Chronic inflammation is a known risk factor for cancer. B. coagulans may help reduce inflammation in the gut and throughout the body, thereby lowering the risk of cancer development. The production of short-chain fatty acids (SCFAs) from the fermentation of dietary fibers by B. coagulans can also have anti-inflammatory effects, further supporting its potential role in cancer prevention. Different strains of B. coagulans may exhibit varying effects on cancer prevention. Research indicates that specific strains may have unique properties that enhance their ability to support gut health and immune function, which are critical in the context of cancer prevention. In conclusion, while more research is needed to fully understand the mechanisms by which Bacillus coagulans may contribute to cancer prevention, its roles in gut health, immune modulation, and antimicrobial activity suggest it could be a valuable component in dietary strategies aimed at reducing cancer risk. While Bacillus coagulans is generally recognized as safe and offers various health benefits, it is important to consider potential negative side effects that may arise from its consumption. Here are some key points regarding the potential adverse effects: Some individuals may experience gastrointestinal discomfort, including bloating, gas, or diarrhea, especially when first introducing B. coagulans into their diet. This is common with many probiotics as the gut microbiota adjusts to the new bacteria. Although B. coagulans is considered safe for the general population, there is a potential risk of infection in immunocompromised individuals or those with underlying health conditions. In rare cases, spore-forming bacteria can lead to infections if the immune system is significantly weakened. Some individuals may have allergic reactions to B. coagulans or its metabolites. Symptoms can range from mild to severe and may include rash, itching, or gastrointestinal distress. It is advisable for individuals with known allergies to consult a healthcare provider before starting any new probiotic regimen. There is a possibility that B. coagulans may interact with certain medications, particularly immunosuppressive drugs. This could potentially alter the effectiveness of these medications or lead to unexpected side effects. Patients should discuss the use of probiotics with their healthcare provider, especially if they are on medication. In some cases, excessive consumption of probiotics, including B. coagulans, may lead to an overgrowth of bacteria in the gut, particularly in individuals with conditions like small intestinal bacterial overgrowth (SIBO). This can exacerbate symptoms and lead to further digestive issues. In conclusion, while Bacillus coagulans is generally safe and beneficial for many, it is essential to be aware of potential negative side effects, particularly for specific populations. Consulting with a healthcare professional before starting any probiotic is advisable to ensure safety and appropriateness for individual health conditions. Bacillus coagulans and Lactobacillus are both important genera of probiotic bacteria, but they have distinct characteristics and applications. Here are the key differences: Bacillus coagulans is a spore-forming bacterium belonging to the Bacillus genus, while Lactobacillus is a genus of non-spore-forming, rod-shaped bacteria. This fundamental difference in their structure affects their survival and functionality in various environments. B. coagulans is known for its high tolerance to extreme conditions, including heat and acidity, due to its ability to form spores. This makes it suitable for use in food products that undergo high-temperature processing. In contrast, Lactobacillus species are more sensitive to heat and may not survive well in harsh conditions. Both genera produce lactic acid, but B. coagulans can also produce other antimicrobial substances such as acetic acid and bacteriocins, which contribute to its broad-spectrum antibacterial activity against various pathogens. Lactobacillus primarily focuses on lactic acid production, which is beneficial for gut health but may not have the same range of antimicrobial effects. B. coagulans has been studied for its potential in managing gastrointestinal disorders, enhancing immune function, and promoting gut health. It has also shown promise in alleviating symptoms of conditions like irritable bowel syndrome and antibiotic-associated diarrhea. Lactobacillus, on the other hand, is widely recognized for its role in maintaining vaginal health and preventing bacterial vaginosis, as well as its general benefits for gut health. Genomic analysis of B. coagulans indicates that it has unique antibiotic resistance genes that are not easily transferable to other bacteria, which may enhance its safety profile. In contrast, Lactobacillus species may have different resistance mechanisms and safety considerations. While both Bacillus coagulans and Lactobacillus are beneficial probiotics, they differ significantly in their taxonomy, survival capabilities, metabolic products, health applications, and genomic characteristics. Understanding these differences can help in selecting the appropriate probiotic for specific health needs. Bacillus coagulans and inulin represent a powerful combination in the realm of probiotics and prebiotics, respectively. Here’s how they work together to enhance gut health and overall well-being: B. coagulans is a spore-forming bacterium known for its resilience in extreme environments, making it an effective probiotic. It can survive high temperatures and acidic conditions, allowing it to reach the intestines intact, where it can exert its beneficial effects on gut health. This bacterium promotes intestinal digestion and regulates the host's symbiotic microbiota, inhibiting the growth of pathogenic bacteria. It also plays a role in normalizing immune system parameters, which can significantly benefit overall health. Inulin is a type of soluble fiber that acts as a prebiotic, providing nourishment for beneficial gut bacteria, including B. coagulans. By promoting the growth of probiotics, inulin helps enhance the overall microbial balance in the gut.It can improve digestive health by increasing stool bulk and promoting regular bowel movements, which complements the digestive benefits provided by B. coagulans. The combination of B. coagulans and inulin can lead to improved gut health. While B. coagulans helps in the digestion and absorption of nutrients, inulin supports its growth and activity, creating a favorable environment for probiotic action. This synergy can enhance the effectiveness of B. coagulans in treating gastrointestinal disorders, such as irritable bowel syndrome (IBS) and antibiotic-associated diarrhea, by providing a dual approach to gut health management. Together, B. coagulans and inulin may also contribute to the management of non-GI conditions, such as obesity and metabolic disorders, by improving gut microbiota composition and enhancing metabolic functions. The ability of B. coagulans to maintain host microbiota homeostasis, combined with the prebiotic effects of inulin, can lead to improved digestion and nutrient absorption, further supporting overall health. In conclusion, the combination of Bacillus coagulans and inulin offers a powerful strategy for enhancing gut health and addressing various health issues. Their synergistic effects can lead to improved digestion, better immune function, and a balanced gut microbiome, making them a valuable addition to functional foods and dietary supplements. When selecting a Bacillus coagulans supplement, consider the following factors to ensure you choose a product that meets your health needs: Different strains of Bacillus coagulans may have varying effects on health. It's important to look for specific strains that have been studied for their probiotic benefits. For instance, certain strains have shown the ability to enhance immune function and support gut health. Bacillus coagulans is known for its spore-forming ability, which allows it to survive harsh gastrointestinal conditions. Choose a supplement that guarantees the viability of these spores until they reach the gut, as this is crucial for their effectiveness. Look for supplements that are backed by clinical studies demonstrating their efficacy. Research has shown that Bacillus coagulans can help regulate gut microbiota, promote digestion, and even support immune health. Some Bacillus coagulans supplements may include prebiotics or other probiotics. These combinations can enhance the overall effectiveness of the supplement by providing additional support for gut health. Ensure that the supplement is manufactured by a reputable company that adheres to good manufacturing practices (GMP). This can help ensure the product is free from contaminants and contains the stated amount of Bacillus coagulans. Check the recommended dosage on the label. Effective dosages can vary, so it’s important to follow the guidelines provided by the manufacturer or consult with a healthcare professional for personalized advice. Depending on your health goals, you may want to choose a Bacillus coagulans supplement that targets specific issues, such as digestive health, immune support, or even cholesterol management. By considering these factors, you can make an informed decision when selecting a Bacillus coagulans supplement that aligns with your health objectives. Bacillus coagulans has been the subject of various scientific studies that highlight its probiotic characteristics and potential health benefits. Here are some key findings from the research: Bacillus coagulans is recognized for its ability to produce lactic acid, which can help regulate gut microbiota and inhibit the growth of pathogenic bacteria. This regulation is crucial for maintaining a healthy digestive system and preventing gastrointestinal disorders. Research has shown that Bacillus coagulans can be effective in treating conditions such as irritable bowel syndrome (IBS), antibiotic-associated diarrhea, and inflammatory bowel disease. Its spore-forming ability allows it to survive the acidic environment of the stomach and germinate in the intestines, where it exerts its beneficial effects. Studies indicate that Bacillus coagulans can normalize immune system parameters and enhance the functional activity of immune cells. This suggests that it may play a role in boosting the host's immune response, which is beneficial for overall health. Bacillus coagulans contributes to creating an anaerobic and acidic environment in the gut, which is unfavorable for many pathogens. This environment promotes the growth of beneficial anaerobic microorganisms, such as Lactobacillus and Bifidobacterium, further supporting gut health. It is important to note that different strains of Bacillus coagulans may exhibit varying probiotic functions. Some studies suggest that combining different strains could maximize the beneficial effects, as the probiotic functions are often strain-dependent. Beyond gastrointestinal health, Bacillus coagulans has been explored for its potential in treating non-GI medical conditions, including bacterial vaginosis, obesity, and even major depression associated with IBS. This broadens the scope of its application in human health. Scientific studies on Bacillus coagulans reveal its significant potential as a probiotic, particularly in supporting gut health, enhancing immune function, and treating various health conditions. The ongoing research continues to uncover the diverse benefits of this remarkable bacterium. GBI 30 6086 is well-known for its use in functional foods and beverages, while MTCC 5856 is commonly used in supplements targeting gut health and immunity. Bacillus coagulans is a powerful probiotic with various health benefits, from digestive support to immune enhancement. With its stability and effectiveness, it stands out among probiotics and is an excellent choice for improving gut health. Benefits: Supports gut health by balancing the microbiome. Helps with digestion and reduces bloating or gas. May improve immune function and reduce inflammation. Aids in managing IBS, diarrhea, and constipation. Bacillus coagulans can survive stomach acid due to its ability to form spores, which are resistant to extreme conditions, including acidic environments. These spores allow the bacterium to pass through the stomach unharmed and germinate in the intestine, where it can exert its probiotic effects. However, studies indicate that it has a limited capacity to colonize the intestinal tract permanently. Overall, its spore-forming capability is crucial for its survival in the harsh conditions of the gastrointestinal tract. Bacillus coagulans has been granted Generally Recognised As Safe (GRAS) status by the US Food and Drug Administration (FDA), indicating its safety for consumption. Studies have shown that it is well tolerated even at high doses, making it suitable for daily use. Additionally, its probiotic characteristics contribute to gut health without significant safety concerns. Overall, B. coagulans appears to be a safe option for regular dietary inclusion. Studies suggest it may alleviate symptoms of IBS, such as bloating and irregular bowel movements. Bacillus coagulans has shown potential in alleviating symptoms of irritable bowel syndrome (IBS), particularly in children, as indicated by some studies. Probiotic therapy, including B. coagulans, is considered a promising approach for treating various gastrointestinal diseases, including IBS. However, the effectiveness may vary among different strains and individuals. Overall, B. coagulans may be beneficial for managing IBS symptoms.
1.Introduction to Bacillus Coagulans
2.How Bacillus Coagulans Works
Creation of Anaerobic Environment:
Reduction of Pathogens:
Production of Short-Chain Fatty Acids (SCFAs): Support for Immune Function:
Prevention of Microbial Imbalance:
Strain-Dependent Benefits:
Through these mechanisms, Bacillus coagulans demonstrates its potential as a valuable probiotic for promoting gut health and supporting the immune system.
3.Health Benefits of Bacillus Coagulans
Improved Digestion:
Enhanced Nutrient Absorption:
Support for Gut Health:
Regulation of Immune Function:
Reduction of Gastrointestinal Disorders:
Production of Beneficial Metabolites:
Strain-Specific Benefits:
Bacillus coagulans is a versatile probiotic that supports digestion, enhances nutrient absorption, promotes gut health, and modulates immune function, making it a valuable addition to dietary regimens for improving overall health.4.Bacillus Coagulans and Cancer Prevention
Gut Microbiota Regulation:
Immune System Support:
Production of Antimicrobial Compounds:
Anti-inflammatory Effects:
Strain-Specific Benefits:

5.Potential Negative Side Effects of Bacillus Coagulans
Gastrointestinal Discomfort:
Infection Risk in Immunocompromised Individuals:
Allergic Reactions:
Interactions with Medications:
Overgrowth in Certain Conditions:
6.Key Differences Between Bacillus Coagulans and Lactobacillus
Taxonomy and Classification:
Survival and Stability:
Metabolic Products:
Applications in Health:
Genomic Characteristics:
7.The Synergistic Benefits of Bacillus Coagulans and Inulin
Probiotic Properties of Bacillus Coagulans:
Prebiotic Role of Inulin:
Synergistic Effects:
Potential for Broader Health Benefits:
8.Choosing the Right Bacillus Coagulans Supplement
Strain Specificity:
Survivability:
Clinical Evidence:
Additional Ingredients:
Quality and Purity:
Dosage:
Targeted Health Benefits:
9.Scientific Studies and Research on Bacillus Coagulans
Probiotic Effects:
Treatment of Gastrointestinal Disorders:
Immune System Support:
Impact on Gut Microbiota:
Strain Variability:
Applications Beyond the Gut:
10.Bacillus Coagulans GBI 30 6086 vs. MTCC 5856
11.Conclusion
12.Thorne bacillus coagulans
13.FAQs
1. Can Bacillus coagulans survive stomach acid?
2. Is Bacillus coagulans safe for daily use?
3. Can Bacillus coagulans help with IBS?
Recent Posts
Sequence Alignment plays a vital role in the subsequent analysis of NGS data, where millions of sequenced DNA fragments (reads) need to be aligned with a chosen reference sequence in a timely manner.
FASTQ files serve as the “raw data files” for any sequencing application, indicating that they are “unaltered.” Consequently, this file format is utilized for performing Quality Checks on sequencing reads. The Quality Check process is typically carried out using the FastQC tool developed by Simon Andrews from Babraham Bioinformatics.
FASTA format is a text-oriented format utilized for depicting either nucleotide sequences or peptide sequences, where nucleotides or amino acids are denoted by a single-letter code.
Mammalian expression systems enable the production of complex, functional recombinant proteins with proper folding and post-translational modifications. These systems are ideal for studying human proteins in a near-native environment, offering advantages in scalability, gene delivery, and purification. HEK293 and CHO cells remain the most widely used hosts, supporting both transient and stable expression strategies for academic and pharmaceutical applications.
Gas Chromatography (GC) stands as one of the most powerful and versatile analytical techniques used to separate and analyze compounds in complex mixtures. At its core, GC enables the identification and quantification of chemical substances based on their molecular composition and retention behaviors during migration through a chromatographic column.